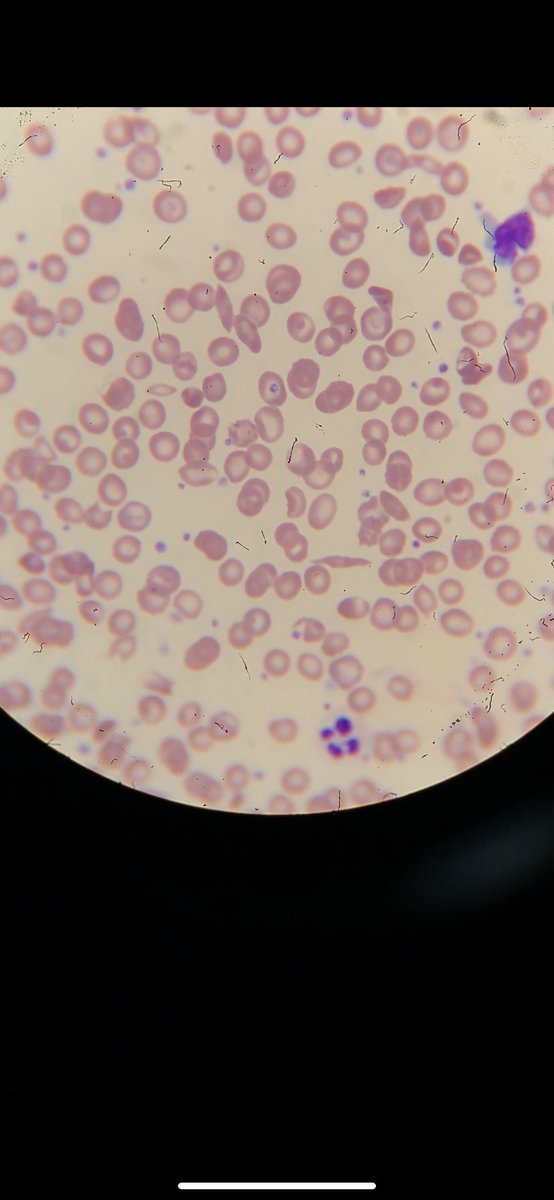
MLS. Tayf tweet media
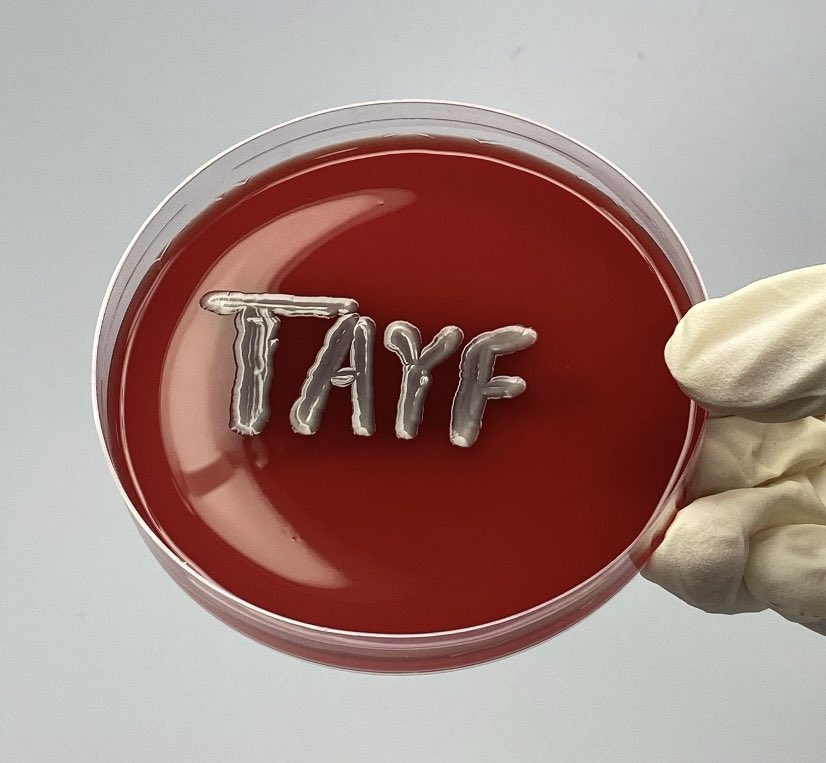
MLS. Tayf tweet media
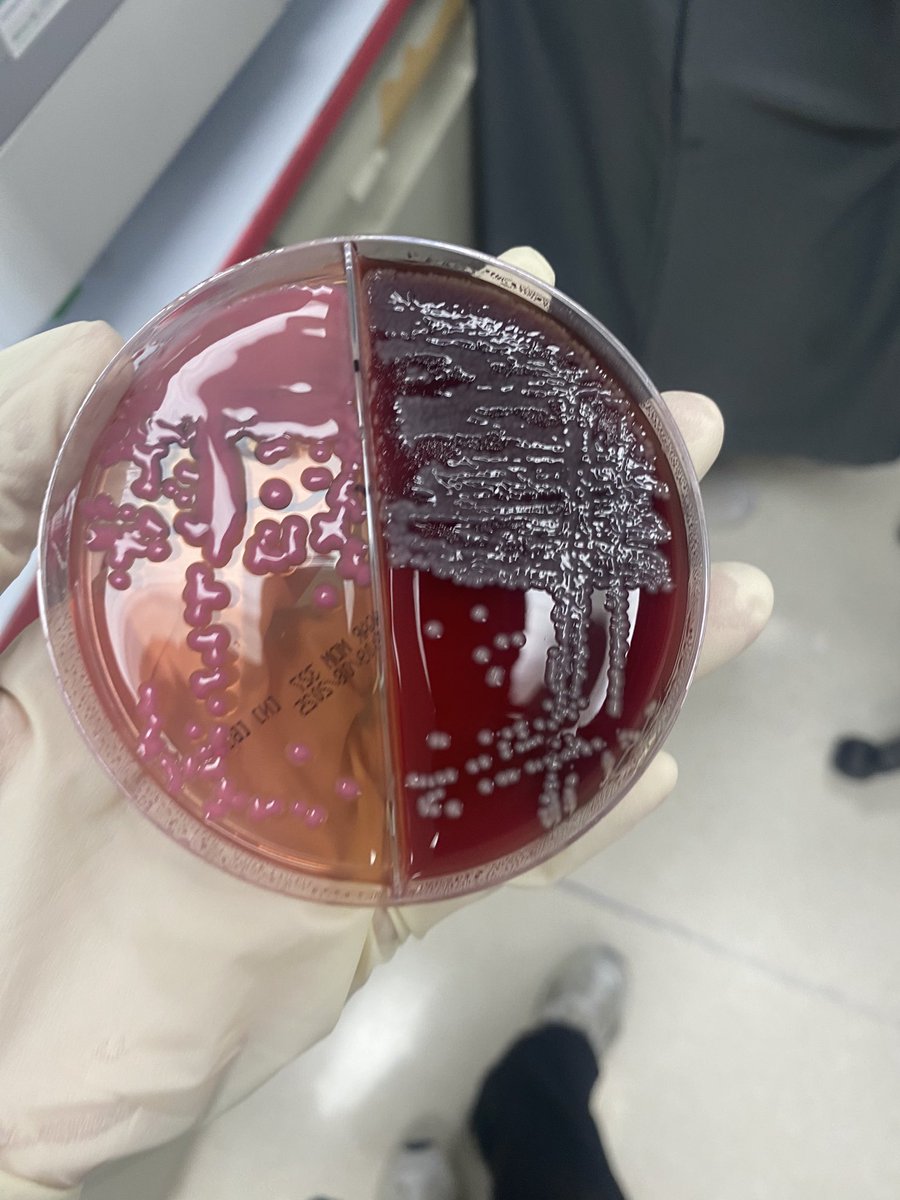
MLS. Tayf tweet media
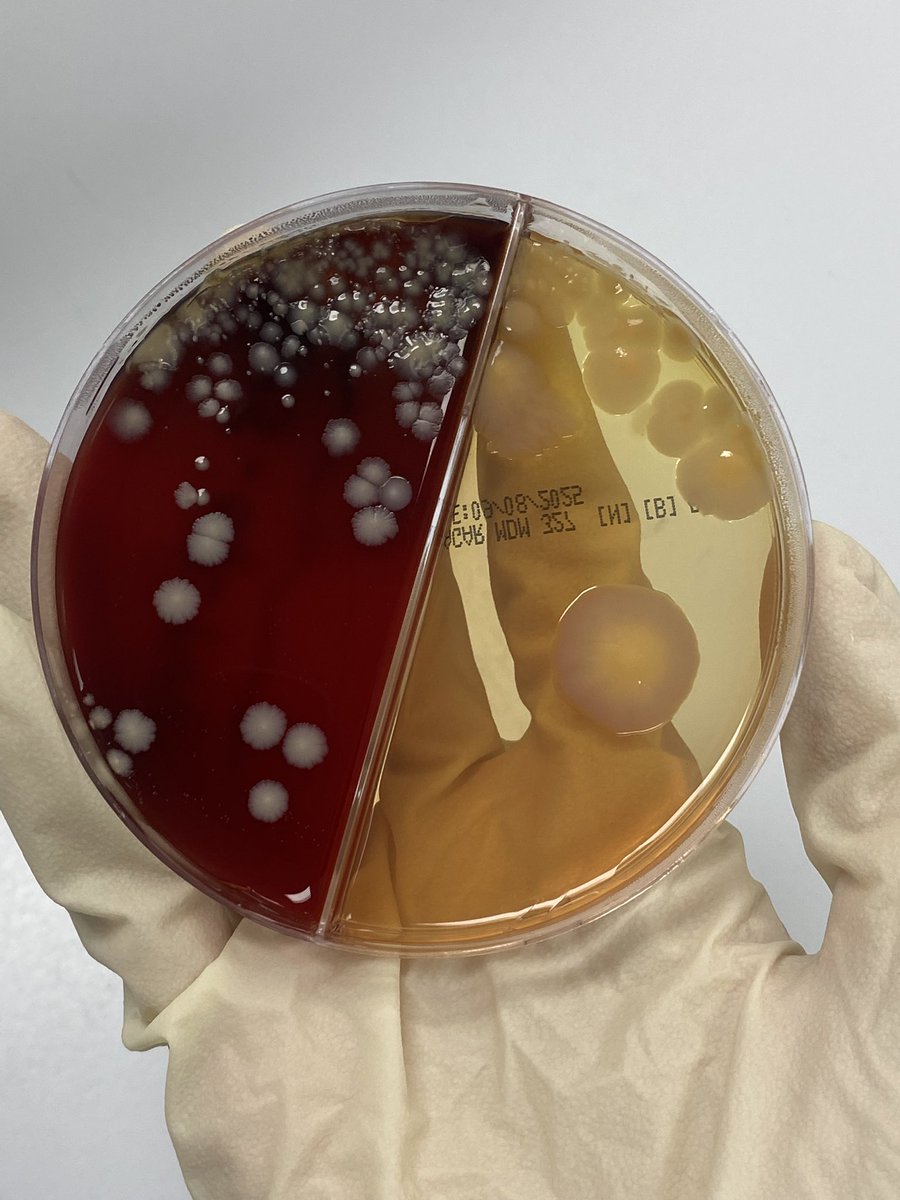
MLS. Tayf tweet media

Sabitlenmiş Tweet
MLS. Tayf
28 posts


MLS. Tayf
@MedLab_ByTayf
Clinical Laboratory Science Intern at (@KFMC_taif)|🔬
Katılım Mart 2023
89 Takip Edilen47 Takipçiler

With Staphylococcus Aureus 🥰🥰

MLS. Tayf@MedLab_ByTayf
في أحد يقدر يمر من مختبر المايكرو بدون ما يكتب اسمه او يرسم على الأقار؟ - شاركونا رسوماتكم🦠🧫
English